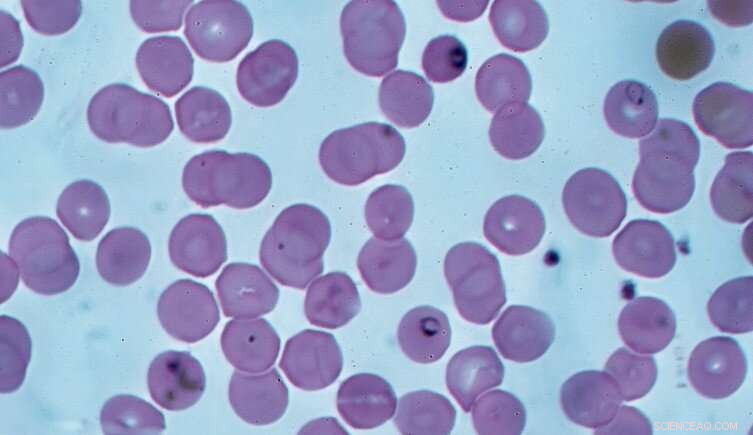
Aestivation in Malaria Mosquitoes: A Breakthrough for Disease Control

Credit: Pixabay/CC0 Public Domain
Mosquitoes can extend their lives by months by halting their growth and reproduction, allowing them to weather harsh conditions.
The process, known as aestivation, offers new opportunities in the fight against malaria.
Mosquitoes in Africa's Sahel region may become dormant during the dry summer months, solving a phenomenon that has puzzled entomologists for almost a century.
A team of African and American scientists marked Anopheles coluzzi mosquitoes, one of the species which carries malaria, with a form of hydrogen to track them throughout their lifespan. They found that around a fifth aestivate for the seven dry months of the year.
This process, which is similar to hibernation, allows them to survive the harsh conditions and re-emerge at the start of the wet season. It explains why the mosquitoes reappear rapidly after the first rains, more quickly than if they had developed from an egg.
The findings may enable mosquitoes to be eradicated while they remain dormant, lessening the impact of malaria in a region where there are almost 20 million infections, and around 10,000 deaths, each year.
Dr. Roy Faiman, the lead author of the study, says, "This study opens the door to the long-term marking of mosquitoes, thus setting the stage for ecological studies we could only dream of a decade ago."
"Using stable isotopes to track mosquito populations will likely help to increase our understanding of how mosquito populations change over time, where they travel and how they persist over the dry season."
The paper, co-authored by scientists from the National Institutes of Health and the Malaria Research and Training Center, was published in the journal Nature Ecology & Evolution.
What are mosquitoes, and how do they spread diseases?
Mosquitoes are a type of fly, with over 3,500 species living around the world. Though they may have a reputation for consuming human blood, the vast majority of these insects are not that interested in us—instead feeding on the blood of a range of animals or nectar from plants.
There are just a handful of species that have adapted to target humans, including Aedes aegypti, Anopholes gambiae and Anopheles coluzzii, which have evolved a preference for the scent of humans.
Only the females of each species feed on blood, as they use the nutrients contained within it to mature their eggs. They may take more frequent blood meals if the availability of other food sources, such as nectar, is lower in the environment.
While the act of feeding itself is not harmful to humans, aside from the irritation from a bite, the parasites the mosquitoes contain are.
Aedes aegypti is a carrier of diseases including dengue fever, chikungunya and yellow fever, while Anopholes gambiae and Anopheles coluzzii are the main carriers of the parasite Plasmodium falciparum in Africa, which causes the most severe forms of malaria.
When infected mosquitoes bite a human, Plasmodium parasites enter the blood, where they migrate to the liver and rapidly divide. The resulting daughter cells then invade red blood cells and continue developing until they return to mosquitoes through another bite.
Each year, around 200 million infections are recorded in Africa, which can cause symptoms including vomiting, seizures and organ failure. In the Sahel region, the majority of these infections take place during and after the rainy season.
As soon as the rains begin, mosquitoes can be found within days, which is significantly shorter than the two weeks they take to develop. This, alongside the fact that mosquito eggs should not be able to survive the dry season, has led to a "malaria paradox" which researchers have attempted to solve for decades.
The parasite Plasmodium falciparum causes the most dangerous forms of malaria in humans. Credit: Dr. Graham Beards, licensed under CC BY-SA 4.0 via Wikimedia Commons.
Dr. Erica McAlister, the Senior Curator of Diptera at the Museum, says, "Mosquitoes have aquatic larvae which may help the larval stages not only avoid competition of food with the adult stage but also offer them a more stable environment."
"They prefer standing water bodies, but these can be very temporary, especially in warmer climes. It is difficult to sample in these habitats to determine what has happened to the populations when the water body does dry up."
One suggestion is that the insects aestivate, taking shelter in a suitable refuge while reducing their reproduction and growth. Laboratory studies have shown this can extend their lifespan by months, but evidence in the wild has been limited.
"There are several possible reasons why demonstrating aestivation in these mosquitoes is complicated," Roy explains. "We've not yet been able to find where the sites that mosquitoes shelter in are, and the exact timing of the beginning of the process is not well known."
"It is also possible that Anopheles coluzzii uses multiple strategies, such as migration, to persist, with one strategy before more successful than others in certain years. There are also many closely related species that live in similar areas which appear to have different persistence strategies, complicating research into any one species."
To try and alleviate some of the uncertainty surrounding this process, the recent study tracked mosquitoes across their lifetime to identify whether they are aestivating in the wild.
Tracking mosquitoes with heavy water
To track the mosquitoes, the researchers used a technique known as stable isotope enrichment. This makes use of an uncommon form of an element which can be tracked after being taken up by a particular organism.
In this case, given the dependence of mosquitoes on water to reproduce, they used deuterium, a form of hydrogen which has an extra neutron than usual. They introduced small amounts of deuterium oxide, otherwise known as heavy water, into certain Anopheles coluzzii breeding pools in Mali during the wet season.
The mosquito larvae in these pools then either absorbed the deuterium directly, or consumed algae and microbes which had been enriched with the isotope. The larvae subsequently hatched and dispersed, with some recaptured during the dry season.
Around a third of mosquitoes from one area were estimated to have deuterium levels significantly above those found naturally in the environment.
At the beginning of the following wet season, the researchers found that the first mosquitoes to emerge had higher levels of deuterium. After around two weeks, the average level dropped when newly hatched mosquitoes, raised without the isotope, had matured and began to appear in the researchers' traps.
While only seven percent of the mosquitoes retained levels of deuterium that were higher than background levels by the next year, the presence of the isotope in the body is known to drop over time as deuterium is exchanged from the more common form of hydrogen.
As a result, the researchers estimated that at least 18% of the marked mosquitoes are believed to have survived through aestivation into the next year. This figure may be an underestimate, as some mosquitoes may have migrated to ponds outside of the study area.
If aestivation is common to this species of mosquito, it opens new possibilities for ways that malaria can be controlled. It may be possible to eradicate populations while they are dormant as the process of aestivation could be targeted by drugs to limit the ability of mosquitoes to survive the dry season.
On the other hand, this discovery also poses challenges for controlling mosquito populations using genetically modified (GM) insects. To date, limited trials have taken place with males altered to pass on genes that kill any female offspring, reducing the size of populations.
If these methods are ever used on a wide scale against Anopheles coluzzii, GM mosquitoes would need to be capable of aestivation or be able to pass on their genes before the dry period begins.
"If released GM mosquitoes do not have the ability to aestivate because of their genetics, the modifications might be purged during every dry season," Roy adds. "This would prevent the establishment of these genes in the wild."
The scientists hope that their research will feed into the development of new ways to control malarial mosquitoes, amid ongoing debate over whether these insects should be eradicated once and for all.